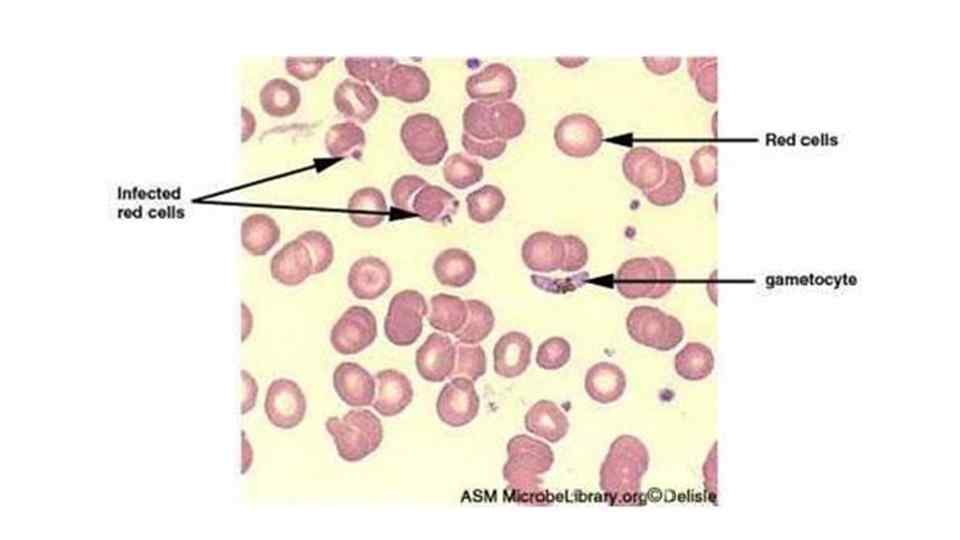

Малярия Выполнил: студент 5 курса ЛД 504 -1 Шишигин Д. В. Якутск, 2017
Малярия Выполнил: студент 5 курса ЛД 504 -1 Шишигин Д. В. Якутск, 2017
 Малярия (итальянский mala aria дурной воздух) — острая протозойная болезнь, вызываемая малярийными плазмодиями Переносчики возбудителей — комары различных видов рода Anopheles. Характеризуется: 1. поражением ретикулогистиоцитарной системы, эритроцитов, 2. интермиттирующей лихорадкой, 3. гепатолиенальным синдромом, 4. анемией 5. рецидивирующим течением болезни.
Малярия (итальянский mala aria дурной воздух) — острая протозойная болезнь, вызываемая малярийными плазмодиями Переносчики возбудителей — комары различных видов рода Anopheles. Характеризуется: 1. поражением ретикулогистиоцитарной системы, эритроцитов, 2. интермиттирующей лихорадкой, 3. гепатолиенальным синдромом, 4. анемией 5. рецидивирующим течением болезни.
 Распространение • Ежегодная заболеваемость малярией составляет более 150 млн. Умирают более 2 млн человек. • Африке, Южной Азии, Океании, Южной и Центральной Америке. Она входит в число основных причин детской смертности в Африке. Всего от малярии ежегодно. Наиболее распространены трехдневная и тропическая малярии, меньшее значение имеет четырехдневная малярия.
Распространение • Ежегодная заболеваемость малярией составляет более 150 млн. Умирают более 2 млн человек. • Африке, Южной Азии, Океании, Южной и Центральной Америке. Она входит в число основных причин детской смертности в Африке. Всего от малярии ежегодно. Наиболее распространены трехдневная и тропическая малярии, меньшее значение имеет четырехдневная малярия.

 Этиология Возбудители малярии - простейшие (Protozoa), относятся к классу споровиков (Sporozoa), семейству Plasmodiae, роду Plasmodium. 4 вида, которые паразитируют у человека: 1. P. vivax - возбудитель трехдневной малярии, 2. P. falciparum - возбудитель тропической малярии, 3. P. malariae - возбудитель четырехдневной малярии, 4. P. ovale - возбудитель малярии овале
Этиология Возбудители малярии - простейшие (Protozoa), относятся к классу споровиков (Sporozoa), семейству Plasmodiae, роду Plasmodium. 4 вида, которые паразитируют у человека: 1. P. vivax - возбудитель трехдневной малярии, 2. P. falciparum - возбудитель тропической малярии, 3. P. malariae - возбудитель четырехдневной малярии, 4. P. ovale - возбудитель малярии овале

Эпидемиология • Источником возбудителя - больной малярией или паразитоноситель, в крови которого присутствуют половые формы возбудителя - гаметоциты. • При тропической малярии они появляются через 7 -10 дней после начала паразитемии, при других видах малярии - не ранее чем после второго приступа. • Продолжительность паразитоносительства составляет при тропической малярии до 1, 5 лет, при трехдневной - до 4 лет, при четырехдневной - десятки лет.
Эпидемиология • Источником возбудителя - больной малярией или паразитоноситель, в крови которого присутствуют половые формы возбудителя - гаметоциты. • При тропической малярии они появляются через 7 -10 дней после начала паразитемии, при других видах малярии - не ранее чем после второго приступа. • Продолжительность паразитоносительства составляет при тропической малярии до 1, 5 лет, при трехдневной - до 4 лет, при четырехдневной - десятки лет.
 • Самки комара откладывают яйца в чистые водоемы со слабопроточной или стоячей водой. • Развитие из яиц взрослого комара - от 7 до 45 дней и может происходить только при температуре выше 15 °С. • Если количество дней в году с температурой воздуха более 15 °С не превышает 30, распространение малярии невозможно, • при количестве таких дней до 90 - вероятность низкая,
• Самки комара откладывают яйца в чистые водоемы со слабопроточной или стоячей водой. • Развитие из яиц взрослого комара - от 7 до 45 дней и может происходить только при температуре выше 15 °С. • Если количество дней в году с температурой воздуха более 15 °С не превышает 30, распространение малярии невозможно, • при количестве таких дней до 90 - вероятность низкая,
 Патогенез • Anopheles (основной хозяин): 1. Попадание зараженной крови в пищеварительный тракт; 2. Гамонты (мужские и женские плазмодии) образуют зиготу, которая превращается в ооцисту; 3. Образование спорозоитов в слюнных железах
Патогенез • Anopheles (основной хозяин): 1. Попадание зараженной крови в пищеварительный тракт; 2. Гамонты (мужские и женские плазмодии) образуют зиготу, которая превращается в ооцисту; 3. Образование спорозоитов в слюнных железах
 • Человек (промежуточный хозяин): 1. В кровь попадают спорозоиты, которые идут в печень; 2. В печени происходит бесполое размножение паразитов – тканевая шизогония, длится 7 -18 дней. Это инкубационный период 3. Образование мерозоитов, которые идут в эритроциты. 4. Эритроцитарная шизогония разрушение эритроцитов. Длится от 48 до 72 часов (апирогенный период) 5. Появление гамонтов.
• Человек (промежуточный хозяин): 1. В кровь попадают спорозоиты, которые идут в печень; 2. В печени происходит бесполое размножение паразитов – тканевая шизогония, длится 7 -18 дней. Это инкубационный период 3. Образование мерозоитов, которые идут в эритроциты. 4. Эритроцитарная шизогония разрушение эритроцитов. Длится от 48 до 72 часов (апирогенный период) 5. Появление гамонтов.
 Гемолиз эритроцитов Приводит к: • Выбросу пирогенов (белки плазмодиев, малярийный пигмент, денатрурированные белки). Эти пирогены приводят к малярийному приступу. • Дилатации сосудов • Повышение вызякости крови • Повышение проницаемости сосудов Это все приводит к риску тромбогеморрагического кровотечения и поражения ГМ и почек.
Гемолиз эритроцитов Приводит к: • Выбросу пирогенов (белки плазмодиев, малярийный пигмент, денатрурированные белки). Эти пирогены приводят к малярийному приступу. • Дилатации сосудов • Повышение вызякости крови • Повышение проницаемости сосудов Это все приводит к риску тромбогеморрагического кровотечения и поражения ГМ и почек.
 Клиническая картина • 3 составляющие: 1. Малярийный приступ 2. Спленогепаомегалия 3. Анемия
Клиническая картина • 3 составляющие: 1. Малярийный приступ 2. Спленогепаомегалия 3. Анемия
 Малярийный приступ • Продромальный период (3 -4 дня) – недомогание, озноб, миалгии, субфебрилитет • Лихорадка до 38 -39 С, озноб, жар, пот • Спутанность сознания • Кожа горячая, тахикардия, арт. Гипотензия • Длительность приступа 6 -12 часов, тропическая малярия – до 11, 5 суток • Промежутки между приступами: тропическая, трехдневная – 48 часов, четырехдневная – 72 часа
Малярийный приступ • Продромальный период (3 -4 дня) – недомогание, озноб, миалгии, субфебрилитет • Лихорадка до 38 -39 С, озноб, жар, пот • Спутанность сознания • Кожа горячая, тахикардия, арт. Гипотензия • Длительность приступа 6 -12 часов, тропическая малярия – до 11, 5 суток • Промежутки между приступами: тропическая, трехдневная – 48 часов, четырехдневная – 72 часа
 Особенность тропической малярии • Исключительно высокая поражаемость эритроцитов (до 50%) • Шизогонии могут локализоваться в головном мозге, внутренних органах. • Приступы более суток • Длительность апирексии часто менее суток • Кожа землистого оттенка
Особенность тропической малярии • Исключительно высокая поражаемость эритроцитов (до 50%) • Шизогонии могут локализоваться в головном мозге, внутренних органах. • Приступы более суток • Длительность апирексии часто менее суток • Кожа землистого оттенка
 Осложнения • Возникают в большинстве случаев при тропической малярии и в начале болезни • Малярийная кома • ИТШ
Осложнения • Возникают в большинстве случаев при тропической малярии и в начале болезни • Малярийная кома • ИТШ
 Диагностика • Клинико-эпидемиологический анамнез • Метод толстой капли • ПЦР
Диагностика • Клинико-эпидемиологический анамнез • Метод толстой капли • ПЦР
 Лечение Этиотропное Малярии овале, трех- и четырехдневной: • Хлорохин по 0, 5 г 2 раза в день с интервалом 6 часов; • При резистентности – Мефлохин, Хинин • Профилактика поздних рецидивов - Примахин на 14 дней по 0, 009 г 3 раза в день
Лечение Этиотропное Малярии овале, трех- и четырехдневной: • Хлорохин по 0, 5 г 2 раза в день с интервалом 6 часов; • При резистентности – Мефлохин, Хинин • Профилактика поздних рецидивов - Примахин на 14 дней по 0, 009 г 3 раза в день
 • Тропическая малярия: • Мефлохин 15 мг/кг 3 раза в день каждые 6 часов в течение 5 дней.
• Тропическая малярия: • Мефлохин 15 мг/кг 3 раза в день каждые 6 часов в течение 5 дней.


